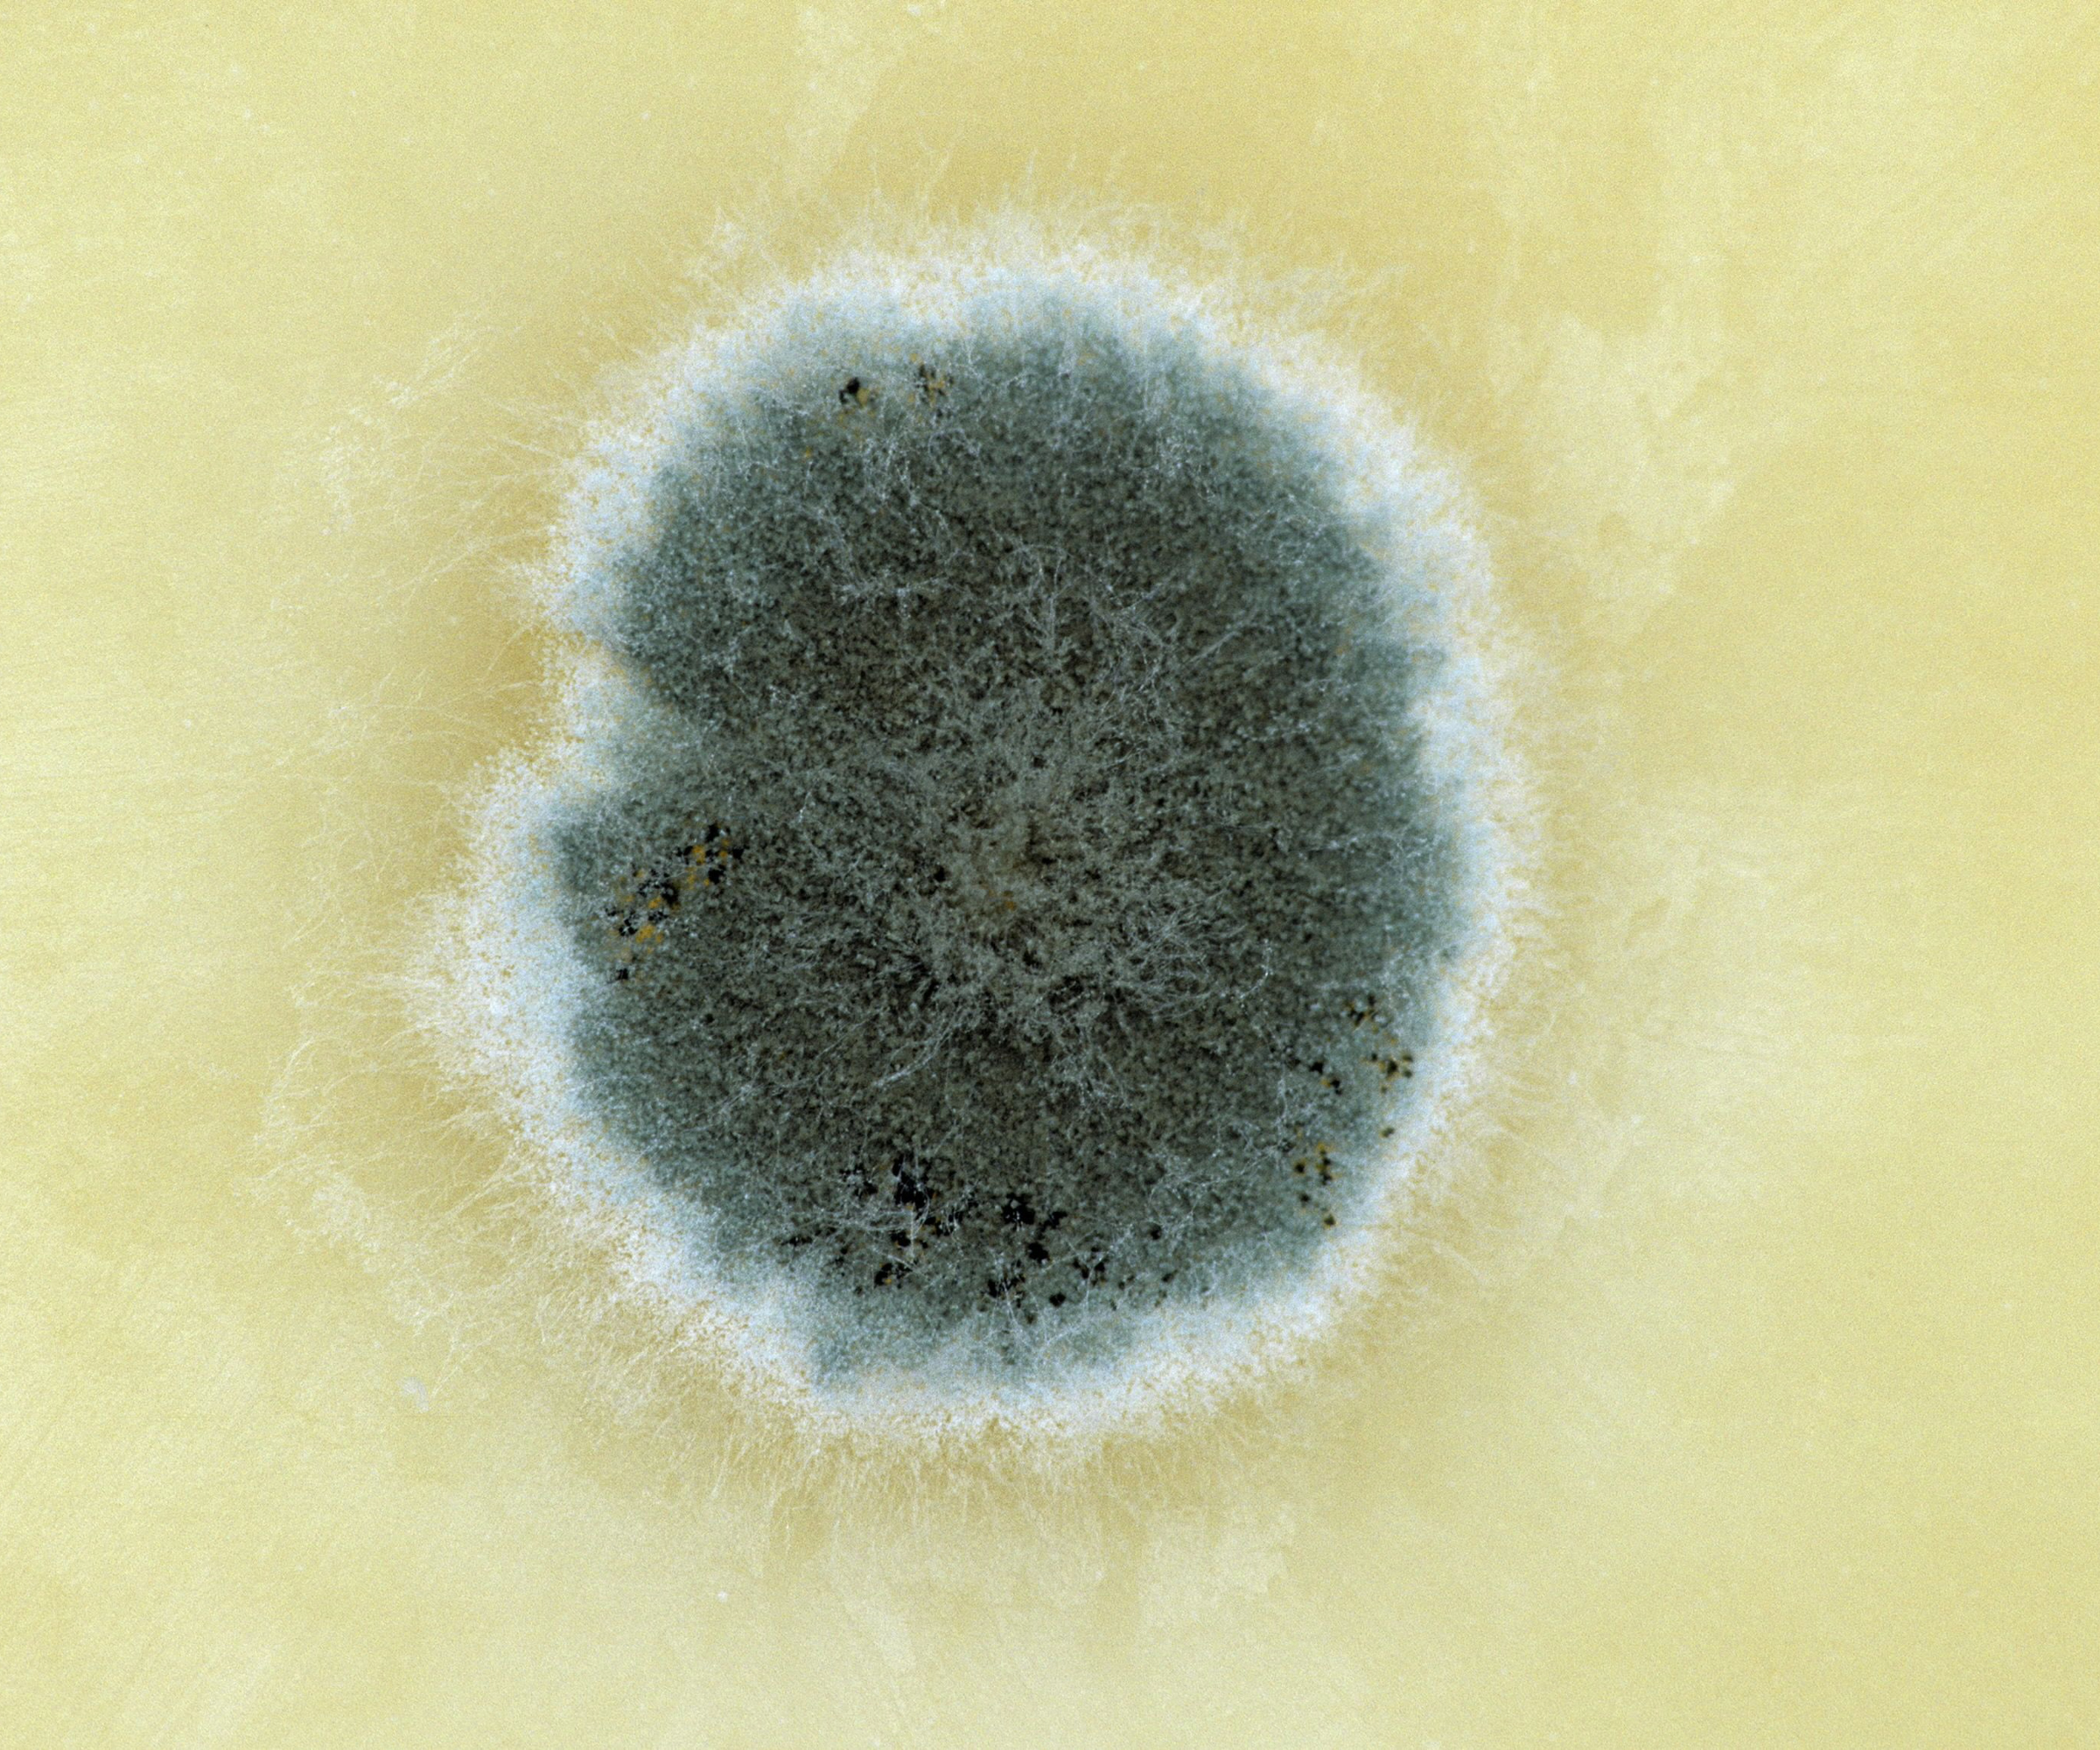
Penicillin
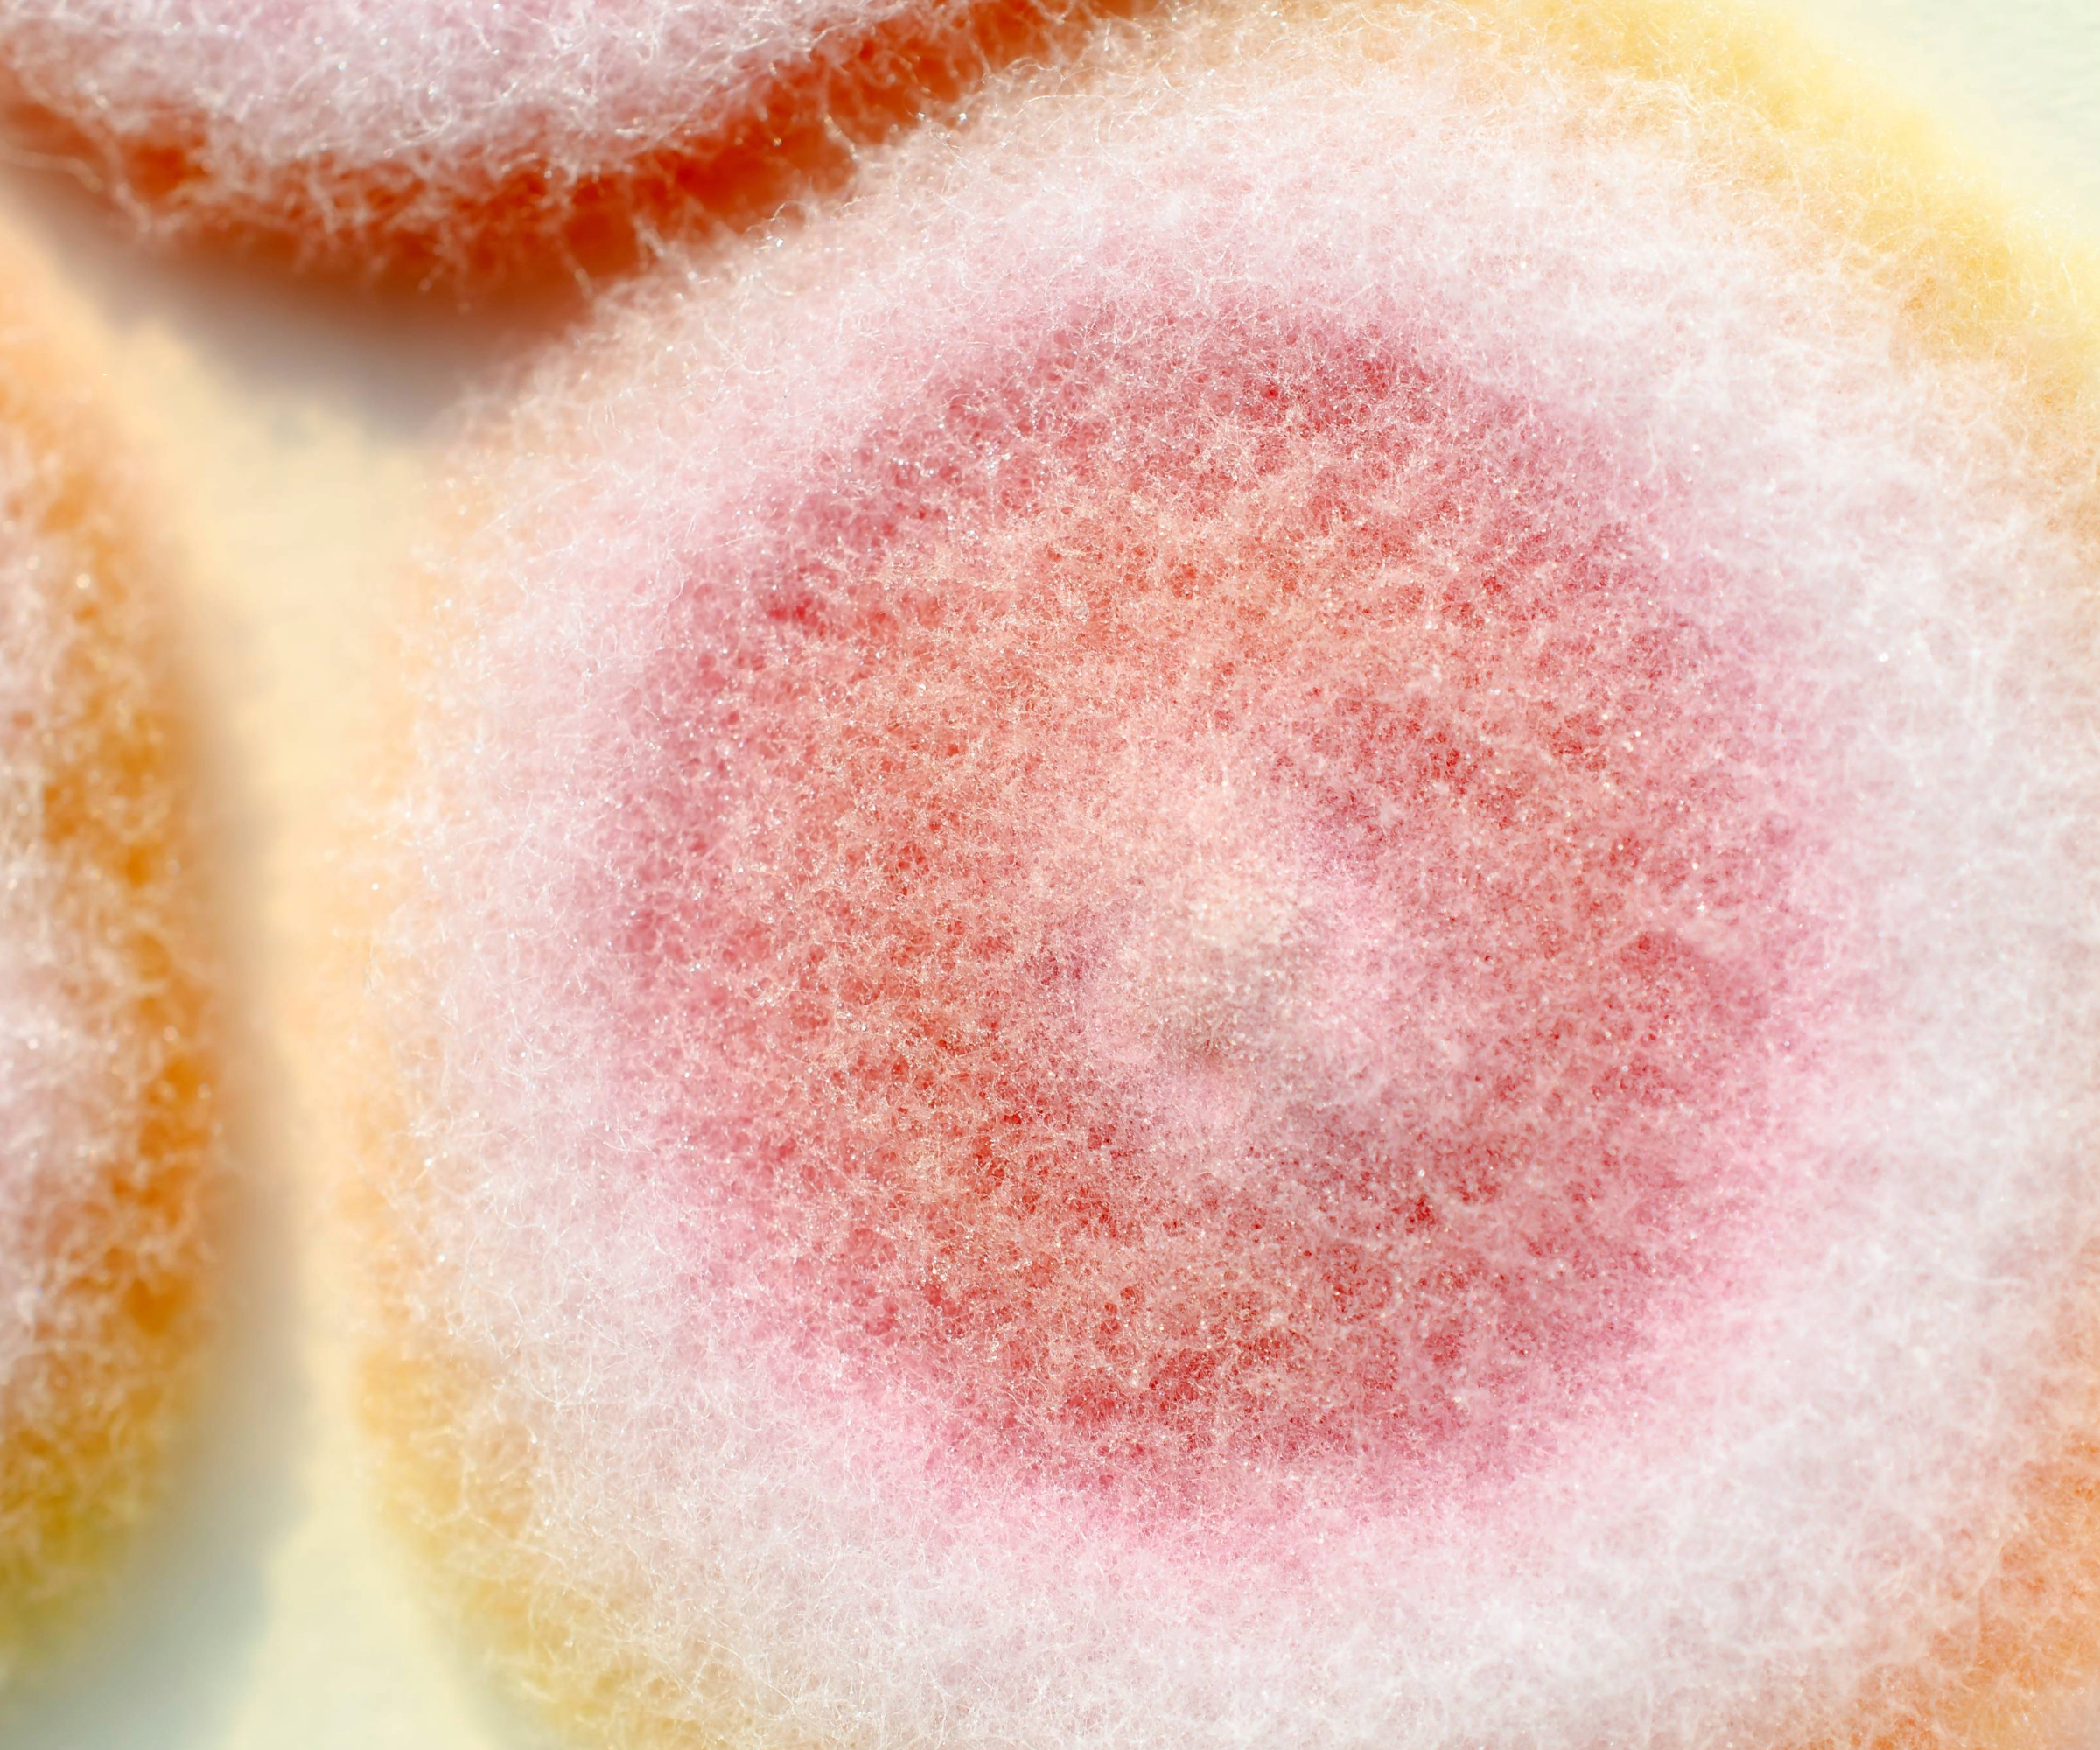
Fusarium
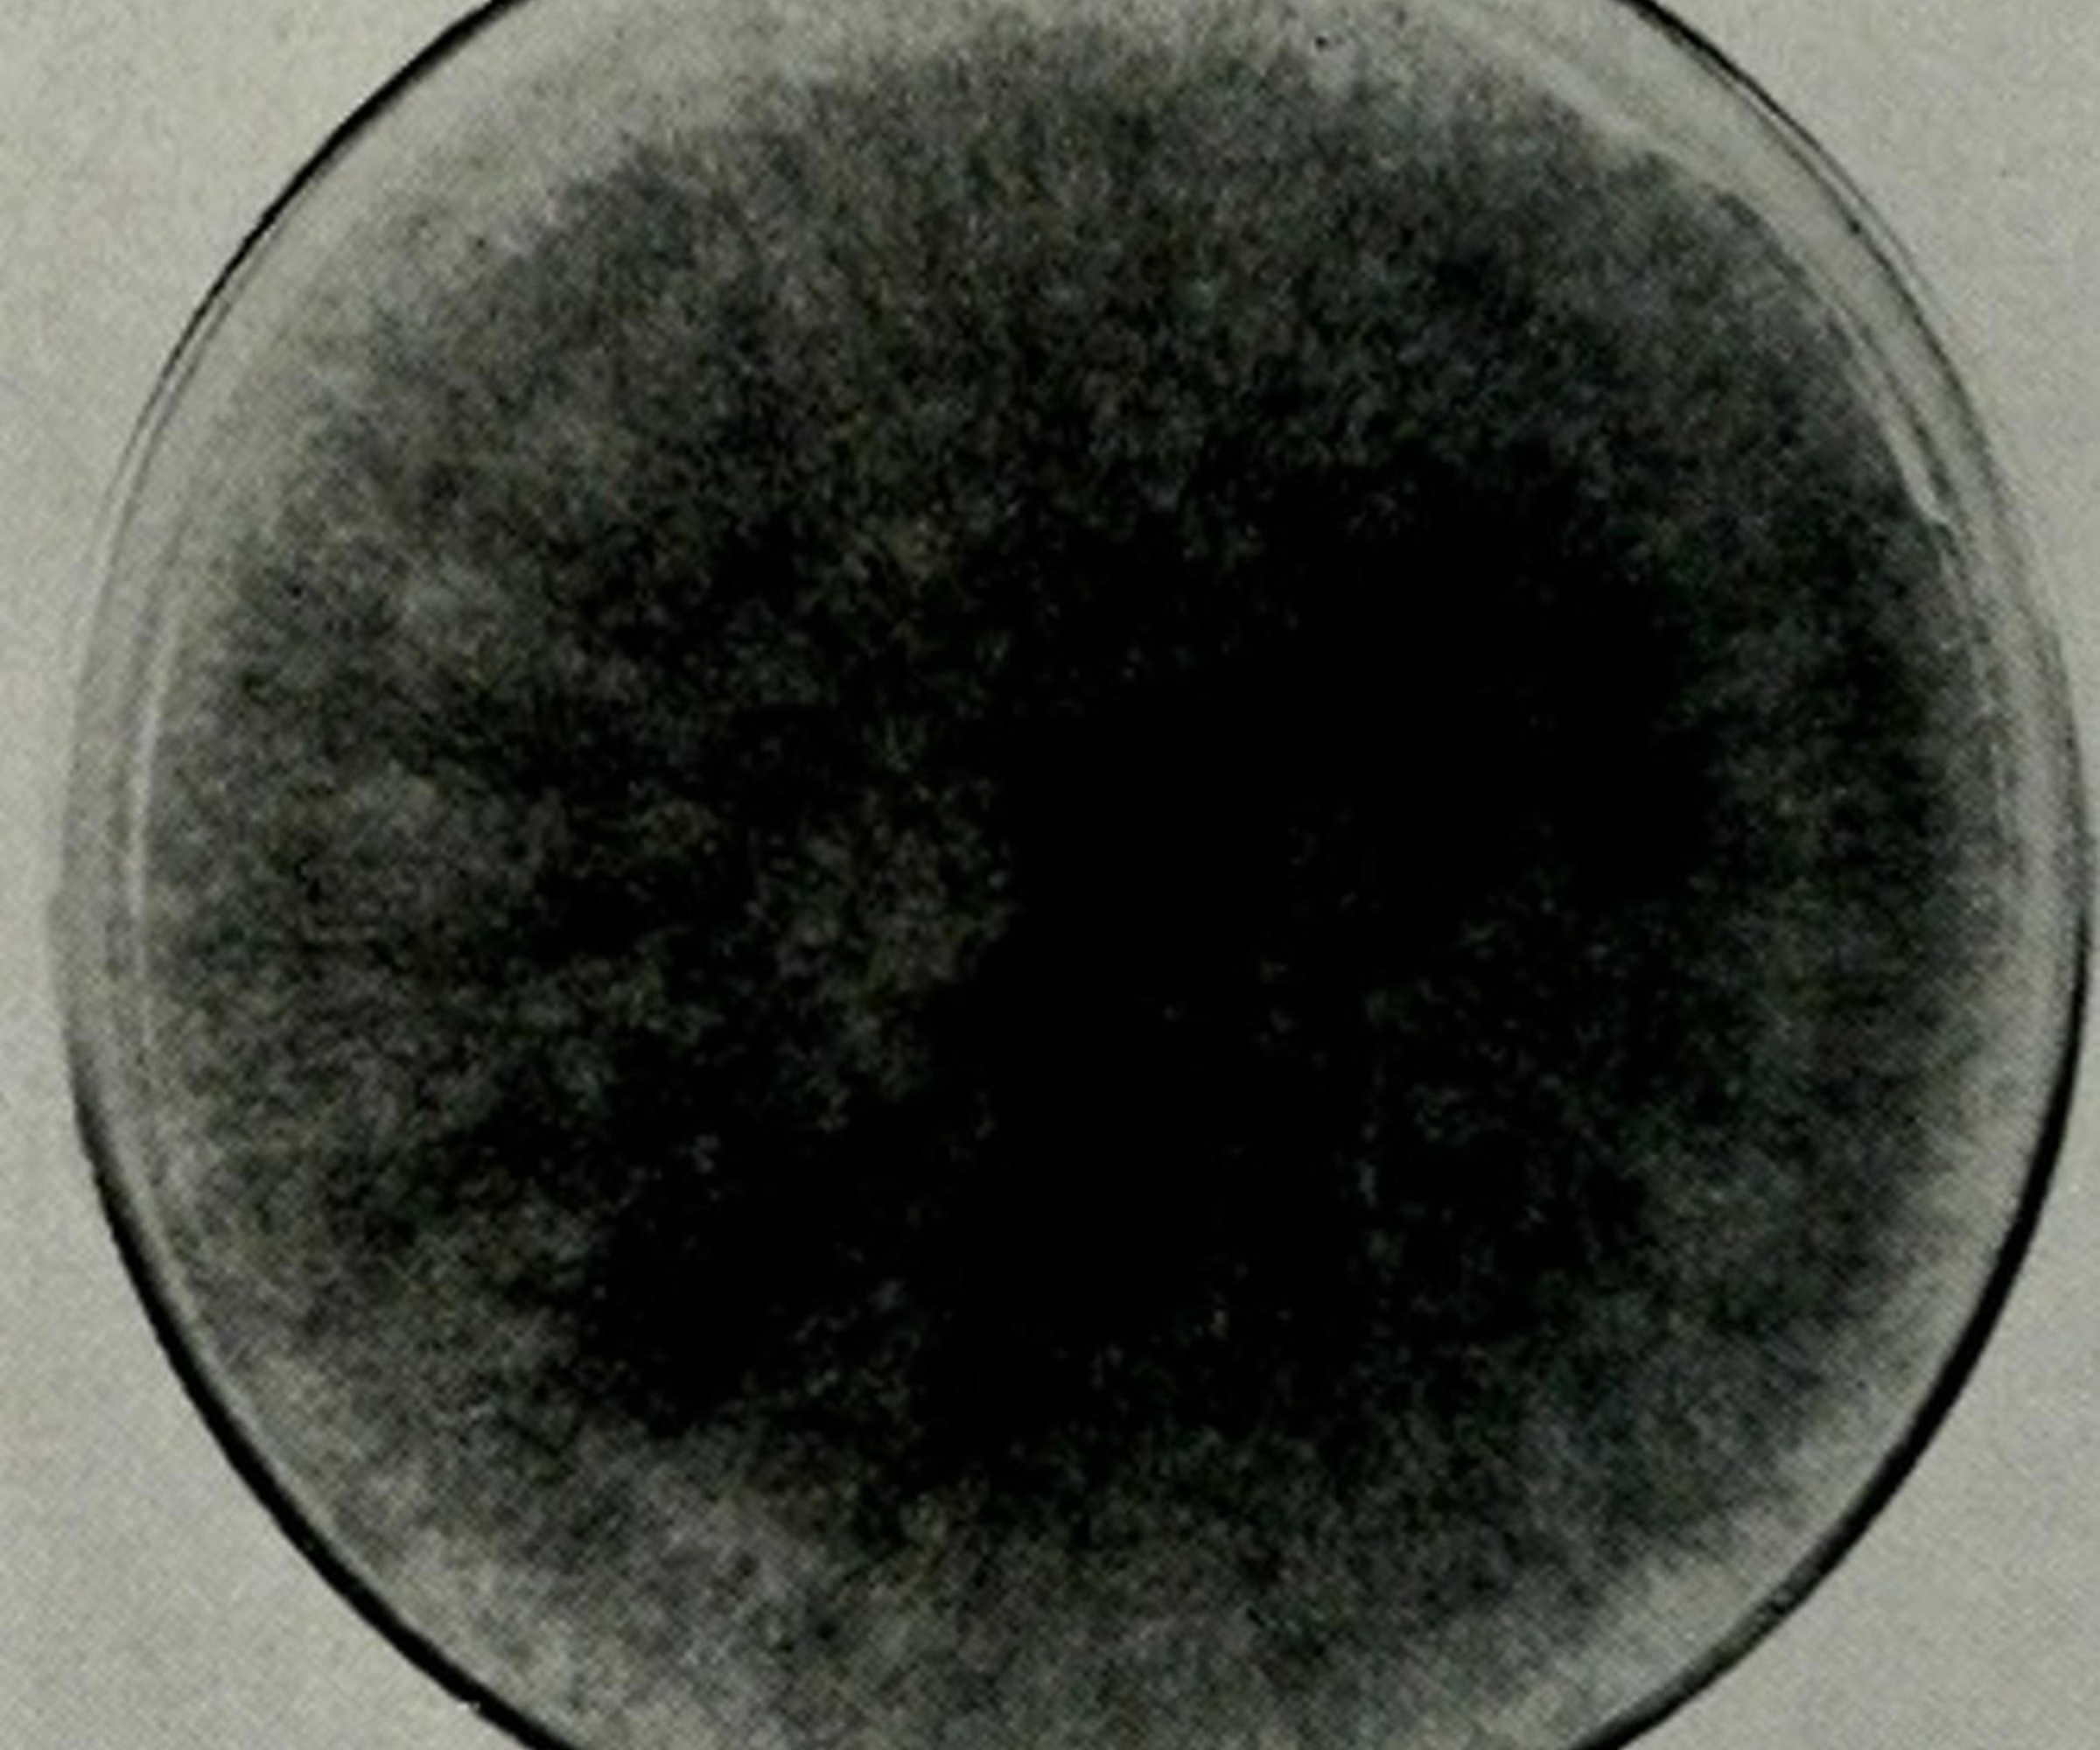
Close-up of Chaetomium

10 types of mould you might find in your home – plus how to get rid of each one
Learn how to identify different types of mould, with expert removal tips from an air quality specialist

There are hundreds of types of mould that grow in homes, and it can cause significant problems if left to fester. As well as being unsightly, it can produce a nasty smell, damage your fixtures, and potentially spread into paint, wallpaper, cloth and plaster.
Spores and mycotoxins can also cause health problems, triggering allergic, respiratory, immune, and inflammatory reactions, as well as long-term conditions such as hypersensitivity pneumonitis This is why mould removal is so important.
Below, we've explained 10 types of mould you need to know about, with expert advice on how to kill it. However, if there is a large amount or it's a particularly dangerous strain, it's always best to leave the removal to professionals.
1. Stachybotrys chartarum (toxic black mould)

There are several types of black mould, and identifying the different variations can be difficult without professional expertise and proper testing. Stachybotrys chartarum appears dark greenish-black, and often has a wet, shiny, or slimy appearance – rather than the dry, more velvety look of other types of mould.
Where it can be found: It thrives on damp walls, particularly behind or on wallpaper and fibreboard, and in cool, damp conditions.
Health issues: Most black moulds come from the same strain as green mould and aren’t too much of a concern – but one type is toxic. Stachybotrys chartarum produces mycotoxins that can be harmful if inhaled or ingested over an extended period.
How to kill it: Michael Zohouri, founder of Pyramid Eco, says, "In my experience, you can’t just spray and wipe. You need to cut out contaminated materials, bag them, and make sure the source of damp is fixed. This is one where I’d almost always recommend professional remediation."
Bring your dream home to life with expert advice, how to guides and design inspiration. Sign up for our newsletter and get two free tickets to a Homebuilding & Renovating Show near you.

Michael Zohouri specialises in tackling mould, damp and ventilation issues, alongside sustainable upgrades such as heat pump installations. His focus is on creating healthier homes that improve air quality and energy efficiency.
2. Cladosporium (non-toxic black mould)

Cladosporium isn’t considered toxic and is generally not dangerous to healthy individuals, but it can cause allergic reactions or worsen asthma symptoms.
Where it can be found: It typically appears black or greenish-brown, with a texture that ranges from powdery to suede-like. Cladosporium can grow on various materials, including fabrics, carpets, wood, and damp walls, but it’s commonly found in areas with high humidity and poor ventilation, like bathrooms, kitchens, and basements in humid months of the year.
Health issues: It can trigger allergic reactions and respiratory issues in some people.
How to kill it: Michael says, "The good news is it usually stays on the surface. A mould remover spray or white vinegar works well. Improve airflow and it tends not to come back."
3. Trichoderma (green mould)

Trichoderma often appears as fuzzy patches that start out white or yellow and turn green-grey as they mature.
Where it can be found: It’s most commonly found in forests and soil, but it can also thrive on paper, wood, and textiles in damp, high-humidity areas. You can use a hygrometer to check if your humidity levels are normal.
Health issues: Some species of Trichoderma can produce mycotoxins, but they are generally considered less harmful to human health than other mould species.
How to kill it: Michael says, "If you catch it early, a good scrub and drying out the area can work. If it’s established, materials may need to be replaced.”
4. Alternaria (brown/green mould)

Another variety of green mould, Alternaria is often dark green or brown, with a velvet-like texture.
Where it can be found: It’s found in damp places like under leaky sinks, bathrooms, and kitchens, and is most common between July and September, but it does grow all year.
Health issues: It spreads quickly, and although most species are not harmful, the spores can cause allergies and asthma-like symptoms. It can also cause respiratory issues and skin irritation in some pets and people.
How to kill it: Michael says, "Use a mould spray and monitor the area – and again, check for the cause of the damp."
5. Mucor (white and fluffy)

Mucor is a fast-growing fungus and will eventually turn a dark grey colour if left long enough. The white 'fluff' is known as Sporangiospores, which are designed to catch the wind to spread its spores far and wide, according to Mold Busters.
Where it can be found: This is often found growing on overripe fruit as well as on anything that is dead or decaying, often in the soil and on plants, but potentially in the house if you discover a dead mouse! Mucor also loves condensation so it can be found on a constantly wet windowsill as well as in any consistently damp areas.
Health issues: Mucor is not considered toxic to healthy humans. That said, it is classed as an allergenic type of mould/fungi, so those with compromised immune systems could develop an infection or respiratory issues if the spores are inhaled, according to a study published by Science Direct.
How to kill it: Michael says, "It’s important to use a HEPA vacuum to safely remove loose spores before wiping down. If the conditions are right, it can cover large areas in days, so act quickly."
6. Penicillium
Where it can be found: Penicillium is velvet-like in texture and appears in a blue-green shade. This type can usually be found as mould on wallpaper, carpets, mattresses and HVAC ducts.
Health issues: It can cause allergy symptoms, which typically occur after allergic individuals inhale mould spores, and spreads quite quickly, so it’s better if you can identify infestations early.
How to kill it: Michael says, "On hard surfaces, a vinegar solution or mould spray works. On anything porous, it’s often safer to discard and replace."
7. Ulocladium
Where it can be found: This type of mould is most commonly found in bathrooms, kitchens and basements that have had water damage or that have been exposed to moisture for long periods of time. It typically appears black in colour and appears in clumps.
Health issues: Ulocladium fungi mostly cause opportunistic infections in immunocompromised individuals.
How to kill it: Michael says, "A good biocide can remove it, but I’d always investigate for leaks or long-term condensation behind it."
8. Fusarium
Where it can be found: Fusarium is often found growing on food but can also appear in wallpaper, carpets, and water-damaged materials. It spreads very quickly and comes in red, white, or pink shades.
Health issues: Fusarium species cause a broad spectrum of infections in humans.
How to kill it: Michael says, "Treatment involves cleaning, drying out cold surfaces using the best dehumidifier, and improving insulation."
9. Chaetomium
Where it can be found: Chaetomium usually appears white in colour but will darken as it matures to a grey, brown, or black shade. It can easily be identified by its musty odour. This type of mould is common on wooden surfaces, on wallpaper, under wet carpets, and in water-damaged areas of your property.
Health issues: It can easily lead to severe allergic reactions and respiratory infections in immune compromised people.
How to kill it: Chaetomium is often mistaken for black mould, so it’s best to leave removals to the professionals.
10. Acremonium

Where it can be found: Acremonium typically appears in small colonies of grey, pink, white, or orange moist mould patches that turn powdery. This type of mould is found most commonly in drains, drip pans, humidifiers, HVAC cooling coils, and around leaky windows.
Health issues: It can cause human superficial infections including mycetoma, onychomycosis and keratitis.
How to kill it: It often appears with black mould and will require removal by a professional.
Michael Zohouri concludes, "The key thing for all types of mould is to fix the moisture problem that caused it in the first place. You need to treat the causes and remove the mould entirely to stop it from coming back."
If you're struggling to get rid of mould on your skirting boards or want to learn how to remove mould from walls, read our expert guides next.
Sam is based in Coventry and has been a news reporter for nearly 20 years. His work has featured in the Mirror, The Sun, MailOnline, the Independent, and news outlets throughout the world. As a copywriter, he has written for clients as diverse as Saint-Gobain, Michelin, Halfords Autocentre, Great British Heating, and Irwin Industrial Tools. During the pandemic, he converted a van into a mini-camper and is currently planning to convert his shed into an office and Star Wars shrine.
- Megan MilsteadContent Editor





